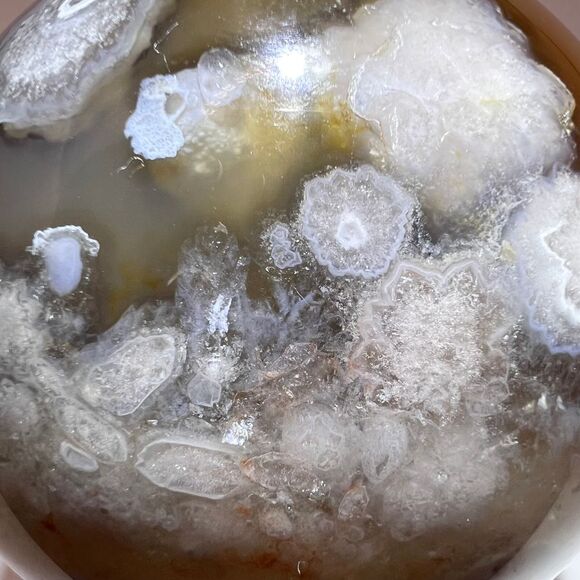
Black Flower Agate Sphere (2) - Picture 6 of 14

Black Flower Agate Sphere (2)
US$32
Pay in 4 interest-free payments of $8
with .
Learn More
.
Size
Like and save for later
Add To Bundle
Black Flower Agate Sphere (2)
A black flower agate sphere features intricate floral-like patterns in dark, grounding hues, symbolizing growth and transformation. Metaphysically, it promotes emotional balance, courage, and self-discovery. This stone is said to dispel negativity, inspire confidence, and foster inner peace.
Approximate Measurements
83.30 grams
1.52" diameter
5.0" circumference
Please note natural stones are one of a kind and tend to have imperfections. Certian lighting may alter the crystal's color display in photos.
*stand not included *
Smoke Free | Pet Free Environment
Shipping/Discount

lanas1973
likes this
Trending Now
Find Similar Listings
Account is under Review
Comment posting is temporarily restricted. Our team will reach out to you shortly. To understand why, select
Learn More.